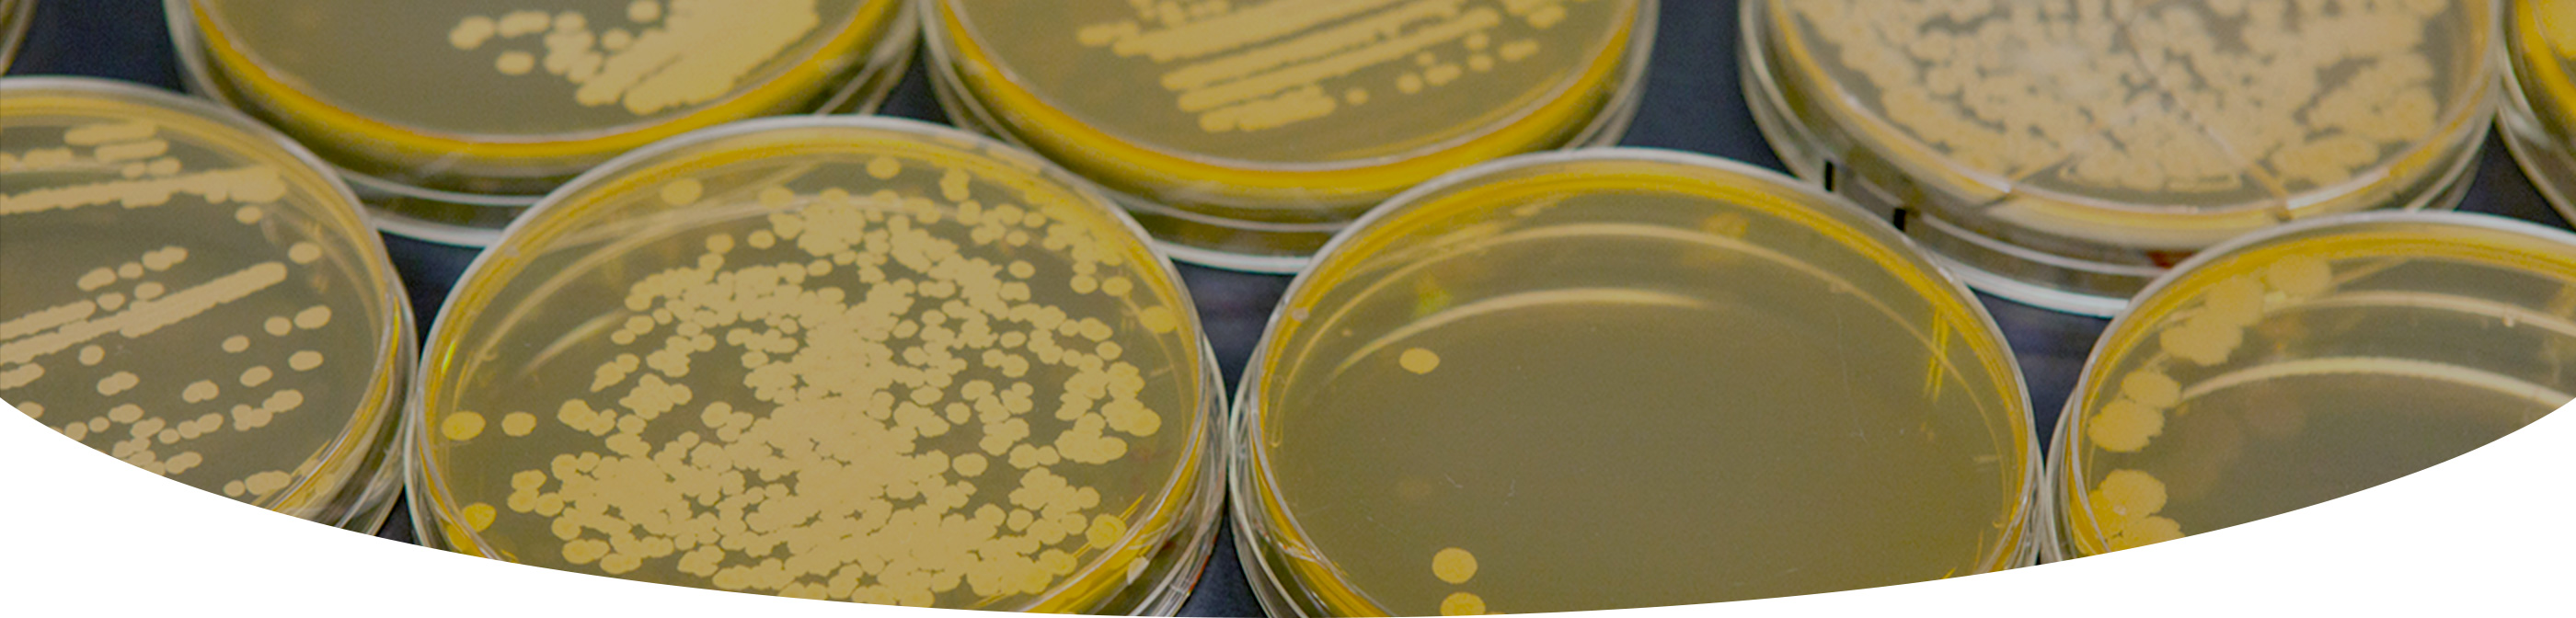
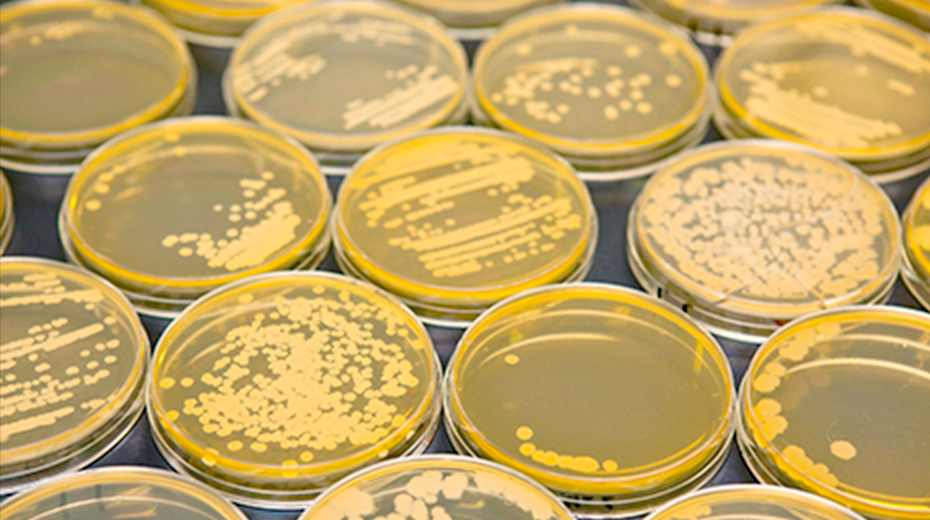

菌のチカラを生かした
納豆づくりへの取り組み
納豆菌を自社で培養・分析し、その性質を知り尽くして製品開発をしています。
菌へのこだわり
納豆菌はすべて自社オリジナル。
その数なんと2200種以上。
納豆菌は枯草菌の一種で、稲のわらに付着しています。糸引納豆は、この納豆菌が煮豆に偶然作用してできたと言われています。
生育状態や種類によって菌の特徴が異なるため、さまざまな環境にある枯れ草などを収集することで、さまざまな種類の納豆菌を採取することができます。納豆研究開発では、収集したこれらの菌を培養して性質を分析するといった地道な研究を日々行っており、その数は2200種以上にもなります。

納豆菌の性質はさまざま。
バランスの良さが大切。
開発する商品によって、においを少なくしたい、粘りを強くしたい、食感をやわらかくしたいなど菌への要望はさまざま。
例えばにおいを少なくする場合、1つのにおい成分だけを少なくしてもにおいのバランスが崩れ、他のにおいが目立つようになることも。本来の糸や味、食感に影響を与えずに、においだけをコントロールするというのは実は難しい課題です。
また、納豆菌の持つ酵素の働きによって、味やにおいも変わってきます。菌の持つ特徴のバランスを保ちながらおいしく仕上げていくことが大切です。

健康をサポートする
特許取得菌を使用したヒット商品
「すごい納豆 S-903」
「すごい納豆 S-903」は、タカノフーズが保有する約2,200株の納豆菌から903番目に登録された「S-903納豆菌」を使用した納豆です。菌の健康効果に着目し、製品化に向けた本格的な研究を始めてから10年余り、ようやく製品にふさわしい品質を実現するに至りました。たれには森永乳業(株)「シールド乳酸菌®」を配合、納豆菌と乳酸菌で毎日の健康をサポートする商品として、「健康寿命への関心」や「納豆の健康効果への期待」の高まりの中、画期的な商品として評価されています。
※S-903納豆菌は2012年特許取得(特許番号第 5090754号)
たれへのこだわり
お互いを引き立てる
絶妙のバランスを求めて
1商品の開発で、50種類以上のたれを
試作することも。
タカノフーズの納豆はたれの種類が豊富。西日本、九州など地域性を重視したもの、昆布、かつおなどだしの種類の違い、そして、しそ、山わさび、といったフレーバーによるものなどがお楽しみいただけます。
たれの味は納豆の味とのバランスが大切、と考えがちですが、実はそれだけではありません。味と味を合わせるのではなく、粒径、粘り、香り、硬さといった納豆の基本的な性質との相性も重要な要素です。納豆をたれの味で食べていただくというよりは、粘りやうま味など納豆本来の多様なおいしさを引き立てるためにたれの味を決めています。

味は文化。地域性も大切。
例えば、九州地方では、甘味料が添加されている甘口醤油の食文化があります。これを尊重して考えると、納豆のたれも甘く仕上げるのが自然なことです。また、関西では、だしといえば昆布だし+薄口醤油、関東ではかつおだし+濃口しょうゆといわれています。こうした各地域の食文化の違いを考慮し、長い間支持されてきた味を納豆のたれの味作りに取り込んでいくことは、とても重要なことだと考えています。
品質へのこだわり
品質へのこだわりは人間の五感で。
品質検査には、検査機器の数値では測定できないものがあります。それは、味やにおいといった人間の五感でしかチェックできない項目で、これらの検査を「官能検査」と呼びます。
官能検査の項目は、外観、糸引き、香り、硬さ、味の5項目。外観はくすんでいなくて色に明るさがあるかどうか、納豆菌の被りが均一かどうか、割れ潰れがないかどうかを確認。糸引きはかき混ぜて箸で持ち上げたときにすぐに落ちないかどうか、また糸に弾力があるかどうかを確認。香りは異臭がないか、硬さは食べてみて適当な硬さか、味は異味がないか、うま味が適度にあるかどうかを確認します。いずれも、たれもからしもかけず、納豆のみ。1パックの所要時間は約1分程度で、1日に数十個の納豆を試食しています。

食卓に上るときに
完熟状態となるように。
これらの官能検査は、出荷した納豆が食卓に上ったときにちょうど食べごろとなるような品質を想定して、複数人で一斉に行われます。
実際には、発酵させて冷蔵庫に入った納豆は、1〜2日程度熟成させ、出荷までおよそ1日、店頭に並ぶまで1〜2日程度かかるため、官能検査の時点ではまだ食べごろではありません。
タカノフーズでは、この食卓での完熟状態を実現するために、検査時の品質に気を配るだけでなく、輸送時間をより短縮するために、全国各地に工場を設けています。

みんなで一斉に官能検査を行う。
